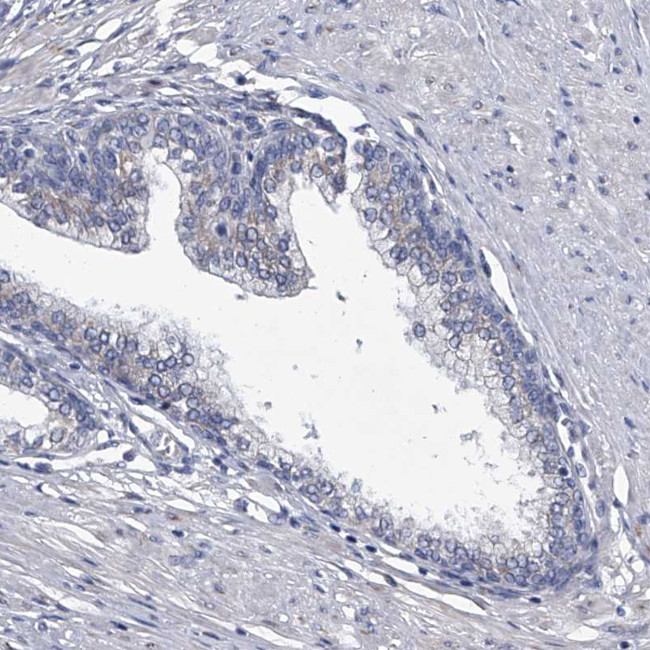
ABCG1 Antibody in Immunohistochemistry (Paraffin) (IHC (P))

Search
Invitrogen
ABCG1 Polyclonal Antibody
{{$productOrderCtrl.translations['antibody.pdp.commerceCard.promotion.promotions']}}
{{$productOrderCtrl.translations['antibody.pdp.commerceCard.promotion.viewpromo']}}
{{$productOrderCtrl.translations['antibody.pdp.commerceCard.promotion.promocode']}}: {{promo.promoCode}} {{promo.promoTitle}} {{promo.promoDescription}}. {{$productOrderCtrl.translations['antibody.pdp.commerceCard.promotion.learnmore']}}
产品信息
PA5-111022
种属反应
宿主/亚型
分类
类型
抗原
偶联物
形式
浓度
规格
纯化类型
保存液
内含物
保存条件
运输条件
RRID
产品详细信息
Immunogen sequence: EYGDQNSRLV RAVREGMCDS DHKRDLGGDA EVNPFLWHRP SEEVKQTKRL KGLRKDSSSM EGCHSFSASC L
Highest antigen sequence indentity to the following orthologs: Mouse - 75%, Rat - 75%.
靶标信息
ATP-binding cassette (ABC) transporter genes are involved in the regulation of the amount of dietary cholesterol retained in the body. The ABC transporter ABCG1 (ABC8) is expressed on the cell surface and in intracellular compartments of cholesterol-laden macrophages and is induced in monocyte-derived macrophages during cholesterol influx mediated by acetylated low-density lipoprotein. In contrast, lipid efflux in cholesterol-laden macrophages, mediated by the cholesterol acceptor HDL(3), suppresses the expression of ABCG1.
仅用于科研。不用于诊断过程。未经明确授权不得转售。
篇参考文献 (0)
生物信息学
蛋白别名: ABC transporter 8; ABCG1p; ATP-binding cassette sub-family G member 1; ATP-binding cassette transporter 8; ATP-binding cassette transporter member 1 of subfamily G; ATP-binding cassette transporter, member 1 of subfamily G; ATP-binding cassette, sub-family G (WHITE), member 1; homolog of Drosophila white; MGC34313; unnamed protein product; white; White protein homolog; white protein homolog (ATP-binding cassette transporter 8)
基因别名: ABC8; ABCG1; WHITE1; WHT1
UniProt ID: (Human) P45844
Entrez Gene ID: (Human) 9619